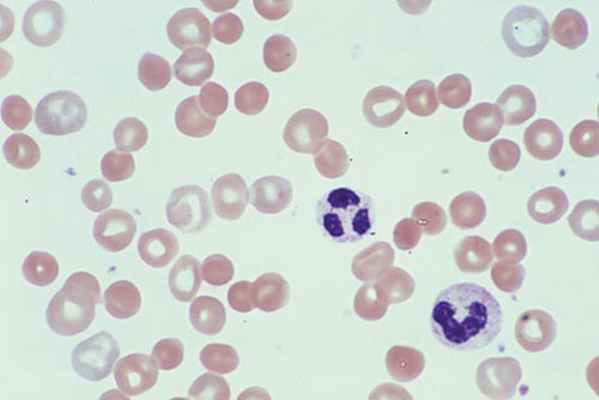
Обзор гемолитической анемии (Overview of Hemolytic Anemia)

Галактоземия
Добавил пользователь Владимир З. Обновлено: 02.11.2025
Галактоземией именуют редкий, детский наследственный недуг, выражающийся в нарушениях углеводного обмена. Природа заболевания лежит в мутации гена, контролирующего ферменты, расщепляющие галактозу.
Молочный сахар, попадая в организм ребенка, в норме, распадается на галактозу и глюкозу. Галактоза в дальнейшем распадается до глюкозы под действием ферментов. Генные мутации, приводят к отсутствию необходимых для этого ферментов, и нераспавшаяся галактоза начинает накапливаться в организме, отравляя его ткани и органы, с дальнейшим поражением нервной системы, печени, органов зрения.
Виды и формы
Выделяют классическую форму недуга и так называемый вариант Дюарте, выражающийся в задержках умственного развития, развитием катаракты и неврологическими проявлениями.
По типу заболевание делят на:
Симптоматика недуга широка и во многом зависит от тяжести болезни. Легкая степень галактоземии выявляется, как правило, случайно.
В ряду основных симптомов стоят непереносимость материнского или коровьего молока и ранний отказ малыша от материнской груди.
Тяжелое течение недуга связано с развитием таких симптомов, как понос, увеличение селезенки и печени, изменение консистенции последней, скопление жидкости в брюшной полости. На коже и слизистых развивается желтуха. Страдает нервная система, с ее стороны наблюдаются нистагм и судороги. Отмечается плохой мышечный тонус и отставание в физическом и нервном развитии. В анализах мочи обнаруживают сахар и белок. Может присоединяться повышенная кровоточивость, объясняемая поражением функций печени (кровотечение из носа, в отделах ЖКТ, из геморроидальных узлов, геморрагическая сыпь на коже).
Диагностика
Диагностическая программа при подозрениях на галактоземию включает в себя:
- Общий осмотр ребенка, как правило, выявляющий асцитный живот и желтушность слизистых и кожи.
- В анамнезе наблюдаются понос, рвота, увеличенная печень, умственная и физическая отсталость, помутнение хрусталика и сниженный мышечный тонус.
- Общий анализ крови нередко показывает развитие анемии.
- В биохимическом анализе крови повышенный уровень галактозы и сниженный уровень глюкозы, сниженный общий белок, повышенный билирубин и уровень печеночных ферментов.
- В анализе мочи избыток галактозы и увеличение белка и сахара.
- пункция печени;
- УЗИ брюшной полости;
- исследование хрусталика с щелевой лампой.
Основное направление в лечении – прекращение воздействия галактозы на организм ребенка. Для этого следует исключить из рациона молоко и молочные продукты. Каши стоит готовить на овощных, мясных, рыбных бульонах или на воде. Тяжелая форма этого заболевания обрекает больного на соблюдение диеты с исключением молока и молочных продуктов на протяжении всей жизни.
Из фармакологических препаратов показаны:
- гепатопротекторы;
- антиоксиданты;
- сосудистые средства;
- кокорбоксилаза, АТФ и комплексы витаминов.
Как средство восстановления нарушенных функций печени показано заменное или обменное переливание крови.
Развитие галактоземии может привести к появлению таких тяжелых осложнений, как:
- цирроз печени;
- бактериальный сепсис;
- внутриглазные кровоизлияния.
Профилактика
Мер специфической профилактики этого недуга не выработано. Его природа наследственна и потому, родителям ребенка, страдающего галактоземией, нужно пройти генетическое консультирование при планировании следующей беременности.
Меры раннего скрининг-исследования (забор крови из пятки на 3-е сутки жизни) помогают выявить активность фермента, ответственного за расщепление галактозы и предупредить развитие тяжелой симптоматики недуга.
Галактоземия
Галактоземия – достаточно редкое наследственное заболевание, суть которого заключается в нарушении углеводного обмена в процессе преобразования галактозы в глюкозу. Так как галактоземия – болезнь наследственная, то причиной ее развития становится мутация гена, который отвечает за расщепляющий галактозу фермент.
Внимание!
Здесь вы сможете выбрать врача, занимающегося лечением Галактоземия Если вы не уверены в диагнозе, запишитесь на прием к терапевту или врачу общей практики для уточнения диагноза.
Статьи на тему Галактоземия:
Симптомы
Причины
Диагностика
Лечение
Симптомы
При такой болезни, как галактоземия, признаки могут сильно отличаться, и определяются они степенью тяжести заболевания. Если болезнь протекает легко, то выявляют ее совершенно случайно. Среди проявлений выделяется плохая переносимость молока и достаточно ранний отказ от груди матери.
При тяжелых случаях наблюдаются такие симптомы галактоземии:
В пищеварительной системе:
- диарея, расстройства стула;
- могут увеличиться в размерах печень и селезенка;
- появляется скопление жидкости в брюшной полости.
В кожных покровах и видимых слизистых появляется желтуха:
- может обнаружиться пожелтение глазных белков;
- желтеет лицо и кожа;
- в последнюю очередь желтеют ладони, подмышки, подошвы, носогубная область.
В нервной системе и зрительных органах:
- мышечные судороги;
- непроизвольные движения глазных яблок;
- снижается тонус мышц;
- появляется катаракта;
- наблюдается отставание в физическом и психическом планах.
В моче могут появиться сахар и белки.
Если болезнь протекает тяжело, то нарушается функция печени и отмечается высокая кровоточивость.
Также на коже может возникнуть геморрагическая сыпь, которая возникает в результате повреждения стенок сосудов.
Галактоземия у новорожденных может проявляться сразу же. После начала кормления молоком у ребенка может наблюдаться понос, рвота, быстрое снижение веса. После может развиться желтуха, увеличиться печень. Еще позже развиваются симптомы поражения нервной системы, что выражается в сильном возбуждении, мышечных судорогах, поражении глаз в виде катаракты (помутнение хрусталика). Развивается цирроз печени, могут проявляться дефекты в умственном развитии.
Формы
Выделяются следующие типы:
Тут у больных проявляется катаракта, проблемы в умственном развитии и неврологических проявлениях.
Считают, что такой тип является причиной развития других заболеваний печени, таких как хронический гепатит. Определяется он случайно при анализе мочи и крови.
В зависимости от степени тяжести выделяются такие виды заболевания:
- легкий тип. Определяется случайно. Проявляется непереносимостью молока;
- средний тип. Признаки появляются сразу после кормления грудным молоком либо молочными смесями. Появляется понос, рвота, снижается масса тела, могут увеличиться печень и селезенка;
- тяжелый тип. Кроме прочих симптомов, появляется асцит – жидкость собирается в брюшной полости, катаракта, поражение почек. Также вероятно заражение крови.
Причины
При таком заболевании, как галактоземия, причины кроются в наследственной предрасположенности. Также выделяются следующие факторы:
- в нормальных ситуациях молочный сахар, поступающий в организм больного малыша, расщепляется на глюкозу и галактозу, а после превращается в глюкозу под действием фермента;
- причиной являются генные мутации;
- при недостатке необходимого фермента продукты обмена и сама галактоза собираются в тканях и крови, оказывая токсический эффект;
- поражается печень, органы зрения, центральная нервная система.
- обменные продукты, такие как галактион, становятся причиной накапливания жидкости в глазном хрусталике, что становится причиной его помутнения и развития катаракты как результат.
Диагностика
- общий осмотр. Наблюдается пожелтение кожи и слизистых оболочек. Увеличивается живот, так как накапливается много жидкости;
- клинические признаки (понос, рвота, снижение тонуса мышц, задержка развития);
- лабораторные данные (общий анализ крови, биохимия крови, определение уровня глюкозы и галактозы, повышение уровня ферментов печени, билирубина, снижение уровня белка);
- анализ мочи (высокий уровень галактозы, высокий уровень белка и сахара);
- дополнительные методы (УЗИ, биопсия печени, диагностика хрусталика глаза);
- может понадобиться консультация медицинского генетика.
Лечение
- исключение вероятности употребления галактозы с пищей (отказ от молока и молокосодержащих продуктов, приготовление пищи на воде или бульоне).
- если болезнь проходит тяжело, то больному может понадобиться соблюдение такого режима на протяжении всей жизни;
- прием сосудистых препаратов, гепатопротекторов, антиоксидантов;
- прием витаминов, АТФ, какарбоксилазов;
- обменное или заменное переливание крови, что используется при нарушении печеночной функции, в том случае, если она неспособна проводить синтез факторов кровяного свертывания, что в будущем становится причиной многих серьезных осложнений.
Осложнения
- Цирроз печени – это тяжелое заболевание печени, при котором проходит необратимое замещение нормальной ткани печени плотной соединительной тканью;
- помутнение хрусталика, кровоизлияния внутрь глаза;
- заражения крови бактериями – бактериальный сепсис.
Профилактика
Как таковая, специфическая профилактика данного заболевания пока не разработана. Поскольку галактоземия у детей является наследственной, то родителям больного ребенка в случае планирования дальнейших беременностей нужно пройти консультации у специалиста-генетика.
На сегодняшний день с целью раннего выявления детей, страдающих этой проблемой, проводится скрининг – программы массового обследования. На третьи сутки жизни у новорожденных берется кровь из пятки и определяется активность фермента, который превращает глюкозу в галактозу.
Галактоземия
Галактоземия является нарушением углеводного метаболизма Обзор нарушений углеводного обмена (Overview of Carbohydrate Metabolism Disorders) Нарушения обмена углеводов - погрешности метаболизма, которые влияют на катаболизм и анаболизм углеводов. Неспособность эффективно использовать метаболиты углеводов характерна для большинства. Прочитайте дополнительные сведения , обусловленным врожденной недостаточностью ферментов, которые преобразовывают галактозу в глюкозу. Симптомы и признаки включают печеночную и почечную дисфункции, когнитивные расстройства, катаракту, и преждевременное угасание яичников. Диагностика включает определение активности ферментов эритроцитов и анализ ДНК. Лечение состоит в отказе от потребления галактозы. Физический прогноз при лечении хороший, но когнитивные и функциональные параметры часто субнормальные.
Дефицит галактозо-1-фосфатуридилтрансферазы
Этот дефицит вызывает классическую галактоземию. Заболеваемость составляет 1/62 000 родов, частота носительства – 1/125. Дети становятся анорексичными и желтушными в течение нескольких дней или недель потребления грудного молока или продуктов, содержащих лактозу. Возникают рвота, гепатомегалия, слабый рост, вялость, понос и сепсис (обычно Escherichia coli), так же как и нарушение функции почек (например, протеинурия, аминоацидурия, синдром Фанкони), что приводит к метаболическому ацидозу Метаболический ацидоз Метаболический ацидоз представляет собой первичное снижение уровня бикарбоната (HCO3 − ), обычно сопровождающееся компенсаторным понижением парциального давления углекислого газа (Pco2). Прочитайте дополнительные сведения и отеку. Может также возникнуть гемолитическая анемия Обзор гемолитической анемии (Overview of Hemolytic Anemia) По окончании срока нормальной продолжительности жизни (около 120 дней) эритроциты удаляются из кровотока. Гемолиз определяется как преждевременная деструкция и, следовательно, укорочение продолжительности. Прочитайте дополнительные сведения .
Без лечения дети остаются низкорослыми, также у них развиваются нарушения когнитивной функции, речи, походки и равновесия в подростковом возрасте; у многих дополнительно возникает катаракта, остеомаляция (вызванная гиперкальциурией) и преждевременное угасание функции яичников. Пациенты с вариантом Дуарте имеют гораздо более легкие проявления.
Дефицит галактокиназы
У пациентов развивается катаракта из-за образования галактитола, который осмотически повреждает волокна хрусталика; идиопатическая внутричерепная гипертензия (псевдоопухоль мозга) встречается редко. Заболеваемость 1/40 000 рождений.
Дефицит уридиндифосфат галактоза 4-эпимеразы
Выделяют доброкачественный и тяжелый фенотипы. Встречаемость доброкачественной формы составляет 1/23000 родов в Японии; нет доступных данных по возникновению более тяжелой формы. Доброкачественная форма ограничивается изменениями в эритроцитах и лейкоцитах и не вызывает каких-либо клинических отклонений. Тяжелая форма вызывает синдром, не отличимый от классической галактоземии, иногда, с потерей слуха.
Диагностика галактоземии
Определение активности ферментов
Лечение галактоземии
Ограничение галактозы в диете
Лечение галактоземии требует изъятия всех источников галактозы в рационе, особенно лактозы (источник галактозы), которая присутствует в грудном молоке, в том числе продуктах на основе молока для грудных детей и подсластителях, и используется во многих продуктах питания. Безлактозная диета предотвращает острое отравление и вызывает обратное развитие некоторых проявлений (например, катаракты), но не может предотвратить нейрокогнитивный дефицит. Многие пациенты нуждаются в дополнительном потреблении кальция и витаминов. Для пациентов с дефицитом эпимеразы потребление некоторого количества галактозы очень важно для обеспечения снабжения уридин-5'-дифосфат-галактозой (УДФ-галактоза) различных метаболических процессов.
Дополнительная информация
Ниже следует англоязычный ресурс, который может быть информативным. Обратите внимание, что The manual не несет ответственности за содержание этого ресурса.
Online Mendelian Inheritance in Man® (OMIM®) database: полная информация о генах и их молекулярной и хромосомной локализации
Авторское право © 2022 Merck & Co., Inc., Rahway, NJ, США и ее аффилированные лица. Все права сохранены.
Галактоземия: что это за болезнь и как с ней жить
Галактоземия — это наследственное заболевание, при котором в организме не перерабатывается галактоза. Накопление галактозы и ее метаболитов приводит к повреждению тканей и органов. Галактоземию диагностируют у детей в первые дни жизни — в этом случае прекращают грудное вскармливание и незамедлительно начинают диетотерапию.
Содержание
Что такое галактоза и почему нарушается ее усвоение?
Все, что мы съедаем, в процессе пищеварения распадается на небольшие молекулы: аминокислоты, жирные кислоты и моносахариды (глюкозу, фруктозу). Дальше организм использует их для получения энергии или как строительный материал. Для того, чтобы расщепить то или иное вещество, нужны ферменты — обычно белковые молекулы, ускоряющие химическую реакцию. Без них реакция будет протекать намного медленнее или не будет вовсе. Ферментов много, и каждый отвечает за свою группу веществ или даже за какое-то одно вещество.
Галактоза — это сахар, содержащийся во многих продуктах питания. Она входит в состав лактозы — другого сахара, который содержится во всех молочных продуктах, в том числе и грудном молоке.
В норме галактоза превращается в организме в глюкозу с помощью ряда ферментов. Из-за мутации в генах, отвечающих за синтез этих ферментов, у больных галактоземией они не вырабатываются, вследствие чего в организме накапливается избыток галактозы и ее производных — метаболитов.
Классическая галактоземия (I типа) обусловлена дефицитом фермента галактозо-1-фосфат-уридилтрансферазы (ГАЛТ).
Чем опасно заболевание?
Избыток галактозы и ее метаболитов приводит к повреждению тканей и органов. Симптомы проявляются у новорожденных в первые дни жизни, поскольку галактоза из грудного молока или молочных смесей попадает в организм и не усваивается должным образом.
Какие метаболиты галактозы токсичны в большом количестве?
При галактоземии в организме больного кроме галактозы может накапливаться галактозо-1-фосфат. Кроме этого, в отсутствии необходимых ферментов метаболизм галактозы протекает иначе: она превращается в галактитол. У больных всегда наблюдается накопление галактитола в крови и тканях и повышение его выделения с мочой.
Какие ткани и органы страдают?
Накопление галактитола в хрусталике глаза обуславливает катаракту — частый симптом галактоземии. Помимо нарушения зрения, у младенцев с галактоземией на фоне грудного вскармливания начинаются такие клинические проявления:
- Симптомы отравления: тошнота, рвота, диарея, вялость;
- Мышечная гипотония;
- Нарушается поражение печени, часто сопровождающиеся желтухой и гепатомегалией печени;
- Кровоточивость, связанная с гипокоагуляцией — нарушением свертываемости;
- Нарушение функции почек.
Наиболее тяжелое и обычно фатальное проявление галактоземии — сепсис, в 90% случаев развивающийся из-за кишечной палочки (Escherichia coli).
Что будет, если не лечить галактоземию?
Без своевременной диагностики и лечения около 75% больных умирает во младенчестве: от сепсиса, печеночной недостаточности и других осложнений.
У выживших детей без лечения развивается хроническая печеночная недостаточность и тяжелое поражение нервной системы, которое приводит к задержке психомоторного развития. В итоге такие дети становятся инвалидами, продолжительность их жизни невелика.
Какие еще бывают типы
- Другой вариант классической галактоземии (тип I) — форма Дуарте. Это более легкая форма, активность фермента ГАЛТ при таком варианте может достигать 25%, а иногда и выше. Тяжелых жизнеугрожающих проявлений у новорожденных обычно не наблюдается, но могут быть желтуха, увеличение печени и задержка физического развития.
- Тип II. Характеризуется мутацией в гене GALK1, кодирующем фермент галактокиназу 1. Симптомы выражены не так сильно, как при классической галактоземии. Часто единственное проявление заболевания — развитие катаракты.
- Тип III. Характеризуется мутацией в гене GALE, кодирующем фермент эпимеразу. Может быть в легкой и тяжелой форме. Легкая форма считается доброкачественной, она связана с дефицитом фермента только в циркулирующих клетках крови. Клинических симптомов в таком случае может и не быть. При тяжелой форме фермента не хватает во всех тканях организма. Симптоматика схожа с классической галактоземией.
- Тип IV. Характеризуется мутацией в гене GALM, кодирующем фермент галактозмутаротазу. Из 8 пострадавших детей, о которых известно, ни у одного не было желудочно-кишечных симптомов или тяжелого нарушения функции печени. У двоих наблюдалась двусторонняя катаракта. Все имели нормальный рост и развитие.
Как часто встречается галактоземия?
Классическая галактоземия встречается у 1 из 30000-60000 тысяч новорожденных. Тип II встречается реже чем в 1 из 100000 случаев. Тип III очень редкий. Тип IV был зафиксирован у 8 человек в мире.

Непереносимость лактозы: что это и в чем причины?
Генетика
Заболевание наследуется по аутосомно-рецессивному типу. Это значит, что если оба родителя здоровы, но имеют копию гена с мутацией, галактоземия у ребенка проявится с вероятностью 25%. В 50% случаев ребёнок будет просто носителем
Как диагностировать
Неонатальный скрининг позволяет диагностировать заболевание на доклинической стадии.
В РФ массовый скрининг проводят на первой неделе жизни: делают анализ крови. Уровень тотальной галактозы (сумма концентраций галактозы и галактозы-1-фосфата) в сыворотке крови не должен превышать 7,2 мг/дл. Если показатели выше, проводят подтверждающую диагностику:
- определение активности фермента ГАЛТ;
- ДНК-исследование. ДНК исследование состоит из двух этапов: 1) скрининг на наиболее частые мутации в гене GALT и вариант Дуарте; 2) полный анализ гена для выявления более редких мутаций. Если мутаций в гене GALT не обнаруживают, то проводят поиск мутаций в генах GALE и GALK1.
Лечение галактоземии
Галактоземия — диагноз, который с человеком навсегда, как цвет глаз или кожи.
Диетотерапия — основной метод лечения симптомов галактоземии.
Необходимо пожизненно исключить все продукты, содержащие лактозу и галактозу:
- любой вид молока, в том числе детские молочные смеси;
- все молочные и молокосодержащие продукты (даже с низким содержанием лактозы).
А также ряд продуктов растительного и животного происхождения, которые содержат галактозиды и нуклеопротеины — вещества, способные метаболизироваться с образованием галактозы. Это такие продукты, как:
- бобовые, в том числе соя (кроме изолята соевого белка);
- шпинат;
- какао, шоколад;
- орехи;
- мясные субпродукты (печень, почки, мозги и т.д.)
На первом году жизни детям с галактоземией дают смеси на основе изолята соевого белка — в них нет растительных галактозидов. При аллергии на соевый белок назначают смеси на основе гидролизатов казеина. Иногда и ту, и другую смесь применяют поочередно.
Введение диеты приводит к купированию клинических симптомов, в том числе катаракты. Но несмотря на это, у больных детей сохраняется риск развития осложнений: задержки физического развития, задержки речи, остеопороза. У девочек повышен риск недостаточности функции яичников.
Детей с галактоземией нужно обследовать тщательнее: регулярно проверять состояние нервной системы, зрения, физического развития и показателей крови, а у девочек — уровень полового развития по достижении пубертата.
Генетический скрининг
Лучше всего, если вы планируете детей, заранее проверить, не являетесь ли вы бессимптомным носителем заболевания.
По результатам Генетического теста Атлас можно получить не только данные о риске развития отдельных болезней и статус носительства наследственных заболеваний, но и особенности метаболизма и предрасположенность к непереносимости некоторых нутриентов. В том числе узнать, нет ли у вас поломок в генах, связанных с галактозой.
Галактоземия

Прочтите и возьмите себе на заметку, особенно если вы молодые люди
В России уже много лет проводится массовое обследование новорожденных для выявления у них нескольких наследственных заболеваний. Такое обследование проводится во многих странах и называется скринингом новорожденных или неонаталъным скринингом.
Целью скрининга новорожденных является, конечно, не само выявление новорожденных с еще не проявившимися наследственными заболеваниями, а их лечение, которое позволяет предотвратить появление клинических симптомов, во многих случаях весьма тяжелых, или даже фатальных. В результате рано начатого и аккуратно проводимого лечения вместо тяжело больных детей, а затем подростков и взрослых, получаются здоровые люди, полноценные члены общества, нередко являющиеся гордостью семьи.
Скрининг новорожденных в России ведется в отношении 5 наследственных и врожденных заболеваний: фенилкетонурии, гипотиреоза, галактоземии, адрено-гениталъного синдрома и муковисцидоза.
ЧТО ТАКОЕ ГАЛАКТОЗЕМИЯ?
Галактоземия является одной из наследственных болезней обмена веществ. Это достаточно редкое заболевание. Галактоземия возникает, если у младенца отсутствует способность расщеплять сахар, содержащийся в молоке. Это происходит из-за нарушения (мутации) в структуре гена, который отвечает за синтез фермента, расщепляющего галактозу, одного из простых Сахаров.
КАК ПРОЯВЛЯЕТСЯ ГАЛАКТОЗЕМИЯ?
Первые признаки болезни могут появиться уже на первой неделе жизни новорожденного, и они связаны с нарушением работы печени. У новорожденного наблюдается желтуха и низкое содержание сахара в крови. Затем могут возникнуть симптомы поражения нервной системы в виде судорог и возбуждения, а так же рвота, понос и другие нарушения со стороны желудочно-кишечного тракта. У больных галактоземией появляется поражение глаз, чаще всего в виде катаракты, нередко развиваются цирроз печени и умственная отсталость. Всех этих тяжелых клинических проявлений галактоземии можно избежать, если во время начать лечить ребенка.
КАК НАСЛЕДУЕТСЯ ГАЛАКТОЗЕМИЯ?
Галактоземия наследуется по аутосомно-рецессивному типу, т.е. больные накапливаются в семье в одном поколении. Схема такого наследования приведена на рисунке, на котором изображен фрагмент родословной семьи с ребенком, больным галактоземией. На родословной мужчины обозначены квадратиком, а женщины - кружочком. Внутри этих квадратиков и кружочков для простоты понимания нарисована только одна хромосома из 23 пар, имеющихся у человека. Эта хромосома может иметь нормальный или мутантный ген галактоземии, последний помечен черной точкой.

У ребенка в обеих хромосомах содержится ген, мутации в котором вызывают галактоземию, и поэтому он болен. У каждого из родителей мутантный ген содержится только в одной хромосоме, а вторая хромосома нормальная, и поэтому они здоровы. У бабки по матери мутантный ген также имеется только в одной хромосоме, как и у деда со стороны отца. Они, как и родители ребенка, здоровы, но передали хромосомы, содержащие мутантный ген, своим детям. Человек, имеющий один нормальный и один дефектный ген, называется носителем мутантного гена. У вторых деда и бабки обе хромосомы содержат только нормальный ген. Таким образом, при рецессивном наследовании болен только тот член семьи, который получил от своих родителей обе хромосомы, несущие мутантный ген. Все остальные члены семьи здоровы, в том числе и те, кто является носителем мутантного гена. В такой ситуации, которая изображена на рисунке, у родителей больного ребенка могут еще появиться больные дети. Вероятность появления больного ребенка в семьях, в которых родители являются носителями мутантного гена, составляет 1/4 или 25%. Эта вероятность не меняется от числа больных или здоровых детей в семье: для каждого следующего ребенка риск, что он будет болен, составляет 25%. Вероятность рождения здорового ребенка, обе хромосомы которого содержат только нормальный ген, составляет также 25%. А 50% детей будут иметь один нормальный и один мутантный ген, они будут здоровы, как их родители.
Многие родители больных галактоземией детей и их родственники, первый раз встретившись с врачом-генетиком, настойчиво повторяют, что у их ребенка не наследственное заболевание, так как в их семье ни у кого из родственников никогда не было такого заболевания. В этих случаях врач-генетик объясняет родителям, что правила наследования бывают разные, и анализ родословной, подобной той, которая изображена на рисунке, позволяет им понять, с какой ситуацией они столкнулись.
ЧТО ТАКОЕ СКРИНИНГ НОВОРОЖДЕННЫХ НА ГАЛАКТОЗЕМИЮ?
ЧТО ДЕЛАТЬ, ЕСЛИ ДИАГНОЗ ГАЛАКТОЗЕМИИ НА СКРИНИНГЕ ПОДТВЕРДИЛСЯ?
Если и при втором тестировании уровень галактозы в крови остается высоким, или уровень измеряемого фермента низким, то это означает, что ребенок болен галактоземией, и семья немедленно приглашается в медико-генетическую консультацию. Здесь семье объясняют, что собой представляет галактоземия и назначают лечение. Если лечение начато рано, то клинические симптомы галактоземии у ребенка не проявятся, и он может расти здоровым, практически не отличаясь от сверстников. Смысл лечения заключается в исключении пищевых продуктов, содержащих галактозу, прежде всего грудного молока и других молочных смесей. Они могут быть заменены специальными смесями, приготовленными на основе сои, которые не содержат галактозу. Успех лечения во многом определяется тем, насколько родители больного ребенка осознали важность диетотерапии и насколько строго они ее выполняют. Обо всем этом и о многом другом семье расскажет врач-генетик во время первого визита семьи в медико-генетическую консультацию. Затем такие визиты станут регулярными. У ребенка будет постоянно контролироваться содержание галактозы в крови и, в зависимости от значений лабораторных показателей, корректироваться состав тех продуктов, которые, с одной стороны, не будут повышать уровень галактозы, а, с другой, обеспечивать нормальный рост и развитие ребенка. Постоянный контакт семьи с врачом-генетиком является залогом успешного лечения галактоземии.
МОГУТ ЛИ СЕМЬИ, В КОТОРЫХ РОДИЛСЯ БОЛЬНОЙ РЕБЕНОК, ИМЕТЬ ЗДОРОВЫХ ДЕТЕЙ?
Для галактоземии возможна дородовая диагностика. Первым шагом в этом направлении является обращение в медико-генетическую консультацию, где врач-генетик определяет показания и возможные методические подходы к дородовой диагностике в каждом конкретном случае. Сама процедура заключается в том, что во время беременности в сроке 9-11 недель или 16-18 недель врач акушер-гинеколог проводит забор очень небольшого количества клеток плода, содержащихся в околоплодной жидкости, плодных оболочках или крови плода, и направляет этот материал в специальную лабораторию пренатальной диагностики. В этой лаборатории врачи лаборанты-генетики проводят молекулярную диагностику, т.е. определяют наличие или отсутствие мутации в гене, отвечающем за галактоземию. В случае положительного результата семья решает вопрос о прерывании беременности больным плодом или настраивается на появление еще одного больного ребенка. Это право выбора остается за семьей.
© 2022 краевое государственное бюджетное учреждение здравоохранения "Красноярский краевой медико-генетический центр" (КГБУЗ "ККМГЦ")
Читайте также:
